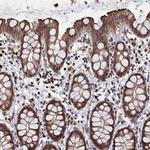
PIGN Antibody in Immunohistochemistry (IHC)

Search
Invitrogen
PIGN Polyclonal Antibody
{{$productOrderCtrl.translations['antibody.pdp.commerceCard.promotion.promotions']}}
{{$productOrderCtrl.translations['antibody.pdp.commerceCard.promotion.viewpromo']}}
{{$productOrderCtrl.translations['antibody.pdp.commerceCard.promotion.promocode']}}: {{promo.promoCode}} {{promo.promoTitle}} {{promo.promoDescription}}. {{$productOrderCtrl.translations['antibody.pdp.commerceCard.promotion.learnmore']}}
产品信息
PA5-59149
种属反应
已发表种属
宿主/亚型
分类
类型
抗原
偶联物
形式
浓度
规格
纯化类型
保存液
内含物
保存条件
运输条件
RRID
产品详细信息
Immunogen sequence: KVDDGVKEIV SMFNHFYGND GKTTFIFTSD HGMTDWGSHG AGHPSETLTP LVTWGAGIKY PQRVSAQQFD DAFLKEWRLE NWK
Highest antigen sequence identity to the following orthologs: Mouse - 89%, Rat - 87%.
靶标信息
PIGN is involved in glycosylphosphatidylinositol (GPI)-anchor biosynthesis. The GPI-anchor is a glycolipid found on many blood cells and serves to anchor proteins to the cell surface. This protein is expressed in the endoplasmic reticulum and transfers phosphoethanolamine (EtNP) to the first mannose of the GPI anchor.
仅用于科研。不用于诊断过程。未经明确授权不得转售。
生物信息学
蛋白别名: GPI ethanolamine phosphate transferase 1; GPI-ethanolamine transferase I; GPI-ETI; hMCD4p; similar to Saccharomyces cerevisiae Mcd4p; MCD4 homolog; Phosphatidylinositol-glycan biosynthesis class N protein; PIG-N; unnamed protein product
基因别名: GPI-ETI; MCAHS; MCAHS1; MCD4; MDC4; PIG-N; PIGN
UniProt ID: (Human) O95427
Entrez Gene ID: (Human) 23556